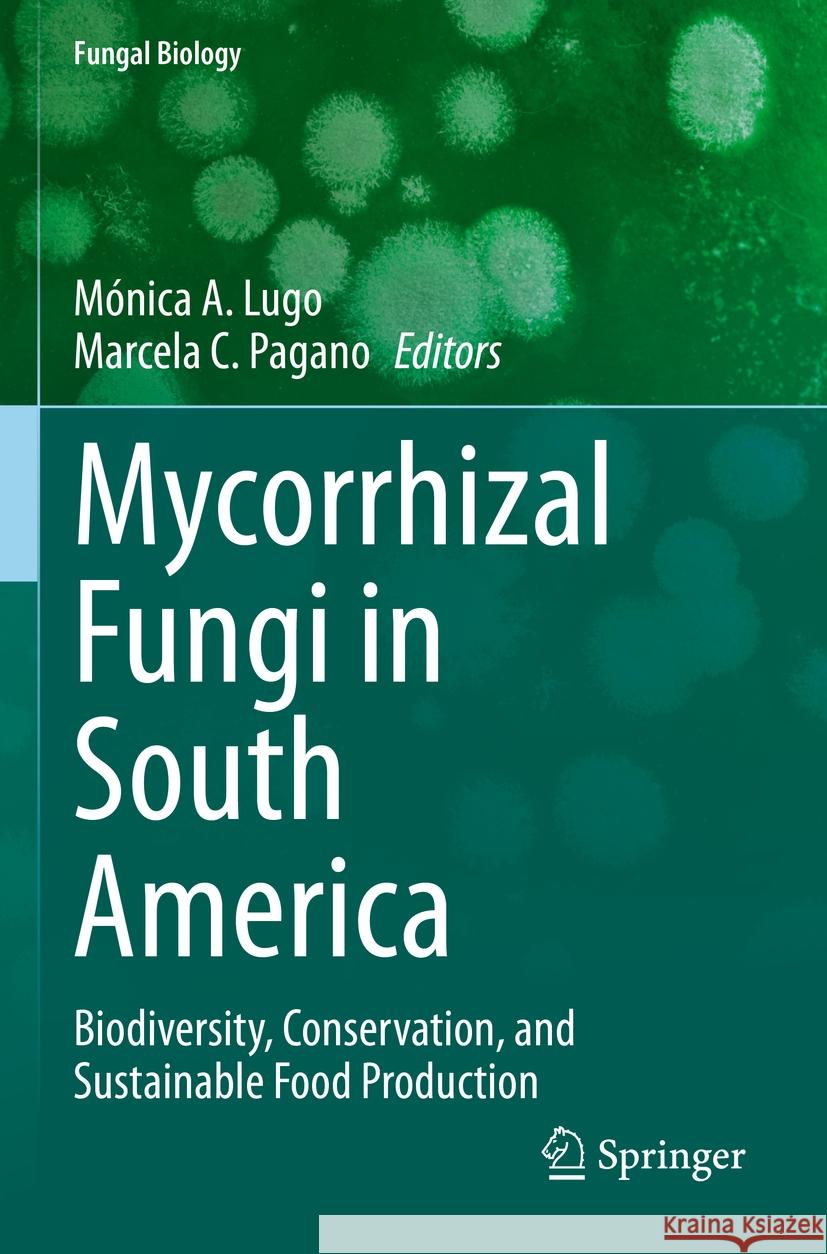
Mycorrhizal Fungi in South America  9783031129964 Springer International Publishing

» książki » Science - Life Sciences - Mycology
 |
Rhizobiont in Bioremediation of Hazardous Waste
ISBN: 9789811606045 / Angielski / Miękka Termin realizacji zamówienia: ok. 5-8 dni roboczych. This book describes many novel approaches of microbial bioremediation including conventional and modern approaches, metagenomics, biosurfactants and nano-based bioremediation. Also presents up-to-date knowledge about biodegradation of solid and liquid contaminants in the rhizospheric zone by plant (rhizo)-microbiome interface. It also illustrates communication pathways based on evolving methodologies, bioinformatic tools which provides insights into the functional dynamics of bioremediation process by the host-microbiome interface. The different chapters explain the mechanism and outcomes... This book describes many novel approaches of microbial bioremediation including conventional and modern approaches, metagenomics, biosurfactants an... |
cena:
726,29 zł |
 |
Dermatophytes and Dermatophytoses
ISBN: 9783030674236 / Angielski / Miękka Termin realizacji zamówienia: ok. 5-8 dni roboczych. This book provides a comprehensive overview on the most recent knowledge in dermatophytic infection biology. Topics covered range from taxonomy, biology and genetics of most common skin disease causing fungi over immunology of dermatophytosis to diagnosis and treatment approaches. Furthermore epidemiology of skin diseases caused by pathogenic fungi is discussed. The book is aimed at researchers and advanced students in infection biology, microbiology and dermatology.
This book provides a comprehensive overview on the most recent knowledge in dermatophytic infection biology. Topics covered range from taxonomy, biolo...
|
cena:
605,23 zł |
 |
Progress in Mycology: An Indian Perspective
ISBN: 9789811623523 / Angielski / Miękka Termin realizacji zamówienia: ok. 5-8 dni roboczych. Indian mycologists have extensively studied various groups of fungi such as soil fungi, aquatic fungi, marine fungi, endophytic fungi, fungi associated with man and animals. Though several books on various aspects of fungi are published, this is the first account of the history and developments in mycology in India. It discusses at length various stages of development of mycology including both classical and biotechnological aspects. It begins with a historical account of Indian mycology, followed by a description of research on fossil fungi. Further chapters cover the latest updates... Indian mycologists have extensively studied various groups of fungi such as soil fungi, aquatic fungi, marine fungi, endophytic fungi, fungi associ... |
cena:
1008,75 zł |
 |
Edible Fungi of Britain and Northern Europe: How to Identify, Collect and Prepare
ISBN: 9780691245195 / Angielski / Miękka / 160 str. Termin realizacji zamówienia: ok. 5-8 dni roboczych. |
cena:
90,75 zł |
 |
Multispecies Biofilms: Technologically Advanced Methods to Study Microbial Communities
ISBN: 9783031153488 / Angielski / Twarda / 321 str. Termin realizacji zamówienia: ok. 5-8 dni roboczych. In an age of antibiotic resistant infections, the study of biofilms is increasingly important. Microbes more than often exist in complex multi-species or polymicrobial communities, making infections difficult to detect, diagnose and treat. Given the increased focus on studying biofilms in research and laboratory settings, particularly under conditions that closely mimic the clinical state, it is important to get an overview of the recent methods, model systems and tools being developed and employed in this context.This book offers readers the opportunity to learn more about current methods...
In an age of antibiotic resistant infections, the study of biofilms is increasingly important. Microbes more than often exist in complex multi-species...
|
cena:
685,93 zł |
 |
Mycorrhizal Fungi in South America: Biodiversity, Conservation, and Sustainable Food Production
ISBN: 9783031129933 / Angielski / Twarda / 465 str. Termin realizacji zamówienia: ok. 5-8 dni roboczych. In order to feed the world, global agriculture will have to double food production by 2050. As a result, the use of soils with fertilizers and pesticides in agronomic ecosystems will increase, taking into account the sustainability of these systems and also the provision of food security. Thus, soil ecosystems, their health, and their quality are directly involved in sustainable agronomical practices, and it is important to recognize the important role of soil microbial communities such as mycorrhizal fungi, their biodiversity, interactions, and functioning. Soil ecosystems are under the...
In order to feed the world, global agriculture will have to double food production by 2050. As a result, the use of soils with fertilizers and pestici...
|
cena:
685,93 zł |
 |
Managing Microorganisms
ISBN: 9781800622111 / Angielski / Twarda Termin realizacji zamówienia: ok. 5-8 dni roboczych. |
cena:
673,90 zł |
 |
Fungal Extracellular Vesicles: Biological Roles
ISBN: 9783030833930 / Angielski / Miękka / 170 str. Termin realizacji zamówienia: ok. 5-8 dni roboczych. This book provides an in-depth overview on the manifold functions of fungal extracellular vesicles (EV) which span from cell-to-cell communication, pathogenicity and stimulation of host’s immunity to export of hundreds of biomolecules. The book summarizes the present knowledge on the impact of extracellular vesicles on fungal biology. Extracellular vesicles participate in fundamental biological processes in all living cells but only during the last 15 years the production and functions of EVs were identified and studied in fungal species too. Up to date more than 50 independent studies...
This book provides an in-depth overview on the manifold functions of fungal extracellular vesicles (EV) which span from cell-to-cell communication, pa...
|
cena:
685,93 zł |
 |
Microbial Enzymes and Metabolites for Health and Well-Being
ISBN: 9781032436197 / Angielski Termin realizacji zamówienia: ok. 5-8 dni roboczych. This up-to-date reference book discusses the synthesis, production, and application of various microbial enzymes and metabolites for health. Chapters include the production of fibrinolytic enzymes, microbial lipases, and bacteriocin production by lactic acid bacteria. It also covers microbial synthesis of alkaloids, terpenoids, and steroids.
This up-to-date reference book discusses the synthesis, production, and application of various microbial enzymes and metabolites for health. Chapters ...
|
cena:
756,05 zł |
 |
Fungal Plant Pathogens: Applied Techniques
ISBN: 9781800620551 / Angielski / Miękka Termin realizacji zamówienia: ok. 5-8 dni roboczych. |
cena:
242,11 zł |
 |
Laboratory Protocols in Fungal Biology: Current Methods in Fungal Biology
ISBN: 9783030837518 / Angielski / Miękka / 261 str. Termin realizacji zamówienia: ok. 5-8 dni roboczych. Mycology has an integral role to play in the development of the biotechnology and biomedical sectors. It has become a subject of increasing importance as new fungi and their associated biomolecules are identified. As this discipline comes to the forefront of research in these sectors, the requirement for a consolidation of available research approaches is required. The First Edition of this book has a few basic and applied protocols. With the Second Edition, this book provides consolidated information on recent developments and the most widely used mycological methods available in the fields...
Mycology has an integral role to play in the development of the biotechnology and biomedical sectors. It has become a subject of increasing importance...
|
cena:
685,93 zł |
 |
Antifungal Drug Resistance: Methods and Protocols
ISBN: 9781071631546 / Angielski Termin realizacji zamówienia: ok. 5-8 dni roboczych. This detailed volume aims to elucidate the molecular mechanisms that underlie antifungal resistance. The book highlights methods to identify and characterize antifungal activity, to define and characterize strains with altered responses to antifungal drugs, to investigate the genetic and molecular mechanisms of these alterations of antifungal drug susceptibility, and, finally, to approach the study of these processes in animal models of fungal infection. Written for the highly successfulMethods in Molecular Biologyseries, chapters include introductions to their respective topics, lists of the...
This detailed volume aims to elucidate the molecular mechanisms that underlie antifungal resistance. The book highlights methods to identify and chara...
|
cena:
645,58 zł |
 |
Progress in Mycology: Biology and Biotechnological Applications
ISBN: 9789811633096 / Angielski / Miękka / 675 str. Termin realizacji zamówienia: ok. 5-8 dni roboczych. Indian mycologists have extensively studied various groups of fungi such as soil fungi, aquatic fungi, marine fungi, endophytic fungi, fungi associated with man and animals. Though several books on various aspects of fungi are published, this is the first account of the history and development in mycology in India. This book is the second volume of the two-volume book "Progress in Mycology: An Indian Perspective".While volume 1 contains the historical aspects, taxonomy and information about the various groups of fungi, this volume focuses majorly on the biotechnological applications of the...
Indian mycologists have extensively studied various groups of fungi such as soil fungi, aquatic fungi, marine fungi, endophytic fungi, fungi associate...
|
cena:
726,29 zł |
 |
Mushroom Handbook
ISBN: 9781528771979 / Twarda / 582 str. Termin realizacji zamówienia: ok. 5-8 dni roboczych. |
cena:
176,43 zł |
 |
Ganoderma Diseases of Tropical Crops
ISBN: 9781800620766 / Angielski / Twarda Termin realizacji zamówienia: ok. 5-8 dni roboczych. |
cena:
566,08 zł |
 |
Grow Your Own Mushrooms: A Beginner's Guide: An Illustrated Guide to Cultivating Your Own Mushrooms at Home
ISBN: 9780760390788 / Angielski / Miękka / 144 str. Termin realizacji zamówienia: ok. 5-8 dni roboczych. |
cena:
65,53 zł |
|
Mycorrhizal Fungi in South America
ISBN: 9783031129964 / Angielski / Miękka Termin realizacji zamówienia: ok. 5-8 dni roboczych. In order to feed the world, global agriculture will have to double food production by 2050. As a result, the use of soils with fertilizers and pesticides in agronomic ecosystems will increase, taking into account the sustainability of these systems and also the provision of food security. Thus, soil ecosystems, their health, and their quality are directly involved in sustainable agronomical practices, and it is important to recognize the important role of soil microbial communities such as mycorrhizal fungi, their biodiversity, interactions, and functioning. Soil ecosystems are under the...
In order to feed the world, global agriculture will have to double food production by 2050. As a result, the use of soils with fertilizers and pe...
|
cena:
484,18 zł |
 |
Multispecies Biofilms: Technologically Advanced Methods to Study Microbial Communities
ISBN: 9783031153518 / Angielski Termin realizacji zamówienia: ok. 5-8 dni roboczych. |
cena:
685,93 zł |
 |
Atlas of Chinese Macrofungal Resources: Volume 1: Overview, Macrofungal Ascomycetes, Jelly Fungi and Coral Fungi
ISBN: 9789819963140 / Angielski Termin realizacji zamówienia: ok. 5-8 dni roboczych. |
cena:
645,58 zł |
 |
Viral and Fungal Infections of the Central Nervous System: A Microbiological Perspective
ISBN: 9789819964444 / Angielski Termin realizacji zamówienia: ok. 5-8 dni roboczych. |
cena:
726,29 zł |













